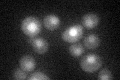
YNL292W
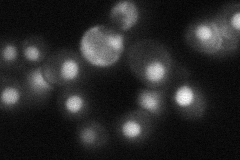
YNL292W
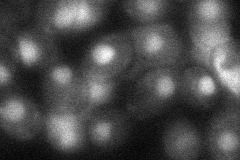
YNL292W

View description
Pseudouridine synthase, catalyzes only the formation of pseudouridine-55 (Psi55), a highly conserved tRNA modification, in mitochondrial and cytoplasmic tRNAs; PUS4 overexpression leads to translational derepression of GCN4 (Gcd- phenotype)
Localization:
Intensity:
Fold change:
Significance:
-
C’ GFP library in SD
nucleus24.77 -
N' NOP1pr-GFP in SD

nucleus158.407 -
N' TEF2pr-mCherry in SD

cytosol224.316 -
N' NATIVEpr-GFP in SD
nucleus45.0499 -
N' TEF2pr-VC and Cyto-VN in SD
nucleus40.7692 -
C’ GFP library in SD+DTT

nucleus21.450.86No -
C’ GFP library in SD+H2O2

nucleus23.550.95No -
C’ GFP library in Starvation Media

nucleus18.380.74Yes -
C’ GFP library on the background of Pup2-DaMP

nucleus -
C’ GFP library on the background of CCT mutant

nucleus27.77241.12092No
